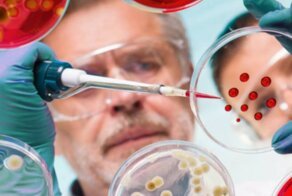

3722
1
Отпадные фотки
Ссылки по теме:
- В Китае зафиксирована смерть человека от хантавируса, который распространяют крысы
- В Сенегале бушует неизвестная болезнь
- Российский штамм: ученые выявили у пациентки 18 мутаций коронавируса
- «Спокойствие!»: инсталляция посвящённая всеобщей панике
- 6-месячная малышка со слабым здоровьем победила коронавирус